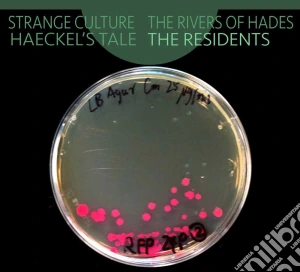

Residents (The) - Strange Culture / The Rivers Of Hades / Haeckel's Tale - 4013438100927
CD
di Residents
prodotto da Klanggalerie, 2016
Residents (The) - Strange Culture / The Rivers Of Hades / Haeckel's Tale. Residents (The) - Strange Culture / The Rivers Of Hades / Haeckel's Tale
Dettagli Bibliografici
Ean
4013438100927
Titolo
Residents (The) - Strange Culture / The Rivers Of Hades / Haeckel's Tale
Interprete
Marca
Data Pubblicazione
2016
Genere
Punti Accumulabili
€ 44.25